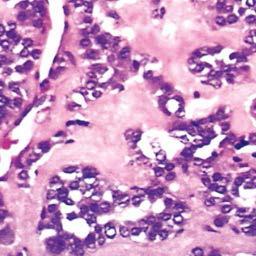

Which of the following statements regarding Grave’s disease is FALSE?
A. Grave’s disease is the most common cause of hyperthyroidism and results from thyroid-stimulating antibodies, mimicing the effects of TSH.
B. People with Grave’s disease have high endogenous production of TSH.
C. Symptoms of Grave’s disease include increased sweating, diarrhea, inability to sleep, weight loss and nervousness or psychic disorders.
D. Grave’s disease is more common in females
E. Grave’s disease is the only form of hyperthyroidism that exhibits exophthalmos
B. This is false. People with Grave’s disease have low endogenous TSH because all of the thyroid hormone they are secreting under the influence of auto-antibodies is feeding back to the pituitary and the hypothalamus to inhibit TSH/TRH, respectively.
this clinical symptom is frequently diagnostic of hyperthyroidism
tachycardia
*he says this is important
Which of the following is NOT a treatment of hyperthyroidism?
A. surgery (thyroidectomy)
B. radioactive iodine to destroy part of the thyroid
C. thiouracil drugs that inhibit T4 synthesis
D. diuretics to control orbital edema
E. beta blockers to slow down heart rate
D
thiouracil drug that inhibits the peroxidase enzyme which catalyzes the conversion of iodide to iodine; side effects include serious liver injury and agranulocytosis
propylthiouracil
*propylthiouracil also acts on peripheral tissues to inhibit monodeiodinase, the enzyme that converts T4 to its active form T3
thiouracil drug that inhibits the peroxidase enzyme and whose serious side effects include congestive heart failure and pulmonary edema
methimazole
life threatening condition that develops in cases of untreated hyperthyroidism whose symptoms include confusion, tachycardia, shaking, sweating and sometimes severe changes in alertness (unconsciousness)
thyroid storm
Which of the following statements regarding hypothyroidism is FALSE?
A. more common in females
B. results from production of antibodies that block the binding of TSH to its receptor
C. includes hashimioto’s thyroiditis, which is the destruction of the thyroid gland (invasion by lymphocytes) due to autoantibodies directed against peroxidase enzyme complex
D. patient may exhibit endemic or idiopathic nontoxic colloid goiter
E. myxedema is the term given for severe hypothyroidism in infants, caused by congenital lack of thyroid gland
E. This is the definition of cretinism (not a commonly used term anymore). Other causes of severe hypothyroidism in infants include genetic defects in the thyroid gland or severe lack of iodine in the maternal diet.
this term refers to extreme hypothyroidism in an adult, and symptoms include bagginess under the eyes and swelling of the lips due to mucopolysaccharide in the interstitial space, as well as fluid accumulation (non-pitting edema)
myxedema
Which of the following statements regarding neoplasms of the thyroid glands is FALSE?
A. they are the most common cancer of endocrine system and the vast majority are easily treatable
B. nodules in males are more likely to be neoplastic than those in females
C. solitary nodules are generally more benign and multiple nodules more often indicate malignancy
D. nodules in younger patients are more likely to be neoplastic than those in older patients
E. nodules that take up radioactive iodine in imaging studies are referred to as “hot” nodules, and are more likely to be benign because they are well-differentiated
C. The opposite is true.
thyroid ____ are solitary, spherical lesions that compress adjacent non-neoplastic thyroid tissue and have well-defined, intact capsules
adenomas
in contrast to thyroid adenomas, these neoplasms lack a well-defined capsule and do not demonstrate compression of adjacent thyroid tissue
multinodular goiters
most thyroid carcinomas, with the exception of which subtype, are well-developed lesions that are derived from the thyroid follicular epithelium?
all EXCEPT medullary carcinoma
*he said this is important
this is the most common malignancy of the thyroid gland (85%) , resulting from activation of the MAP kinase pathway, and is not aggressive so carries an excellent prognosis
papillary thyroid
*note that some of the cells look like they are empty of nuclei

less common type of thyroid carcinoma that is composed of solitary “cold” nodules (ie, don’t take up radioactive iodine) and tends to metastasize to the lungs, bone and liver
follicular thyroid cancer
*note below the destruction of follicles, showing only remnants of thyroglobulin

less than 5% of thyroid cancers are this subtype, which is highly undifferentiated and has 100% mortality rate, and has a number of different underlying mechanisms including inactivation of p53
anaplastic thyroid carcinoma
tumors of this thyroid cancer subset arise from the parafollicular C cells, and can occur in multiple endocrine neoplasia type 2 (MEN2) as part of a familial syndrome
medullary thryoid cancer - remember - this is the only subset that does NOT arise from the follicular epithelium!
*note below the deep staining purple stuff, which is amyloid and is derived from calcitonin